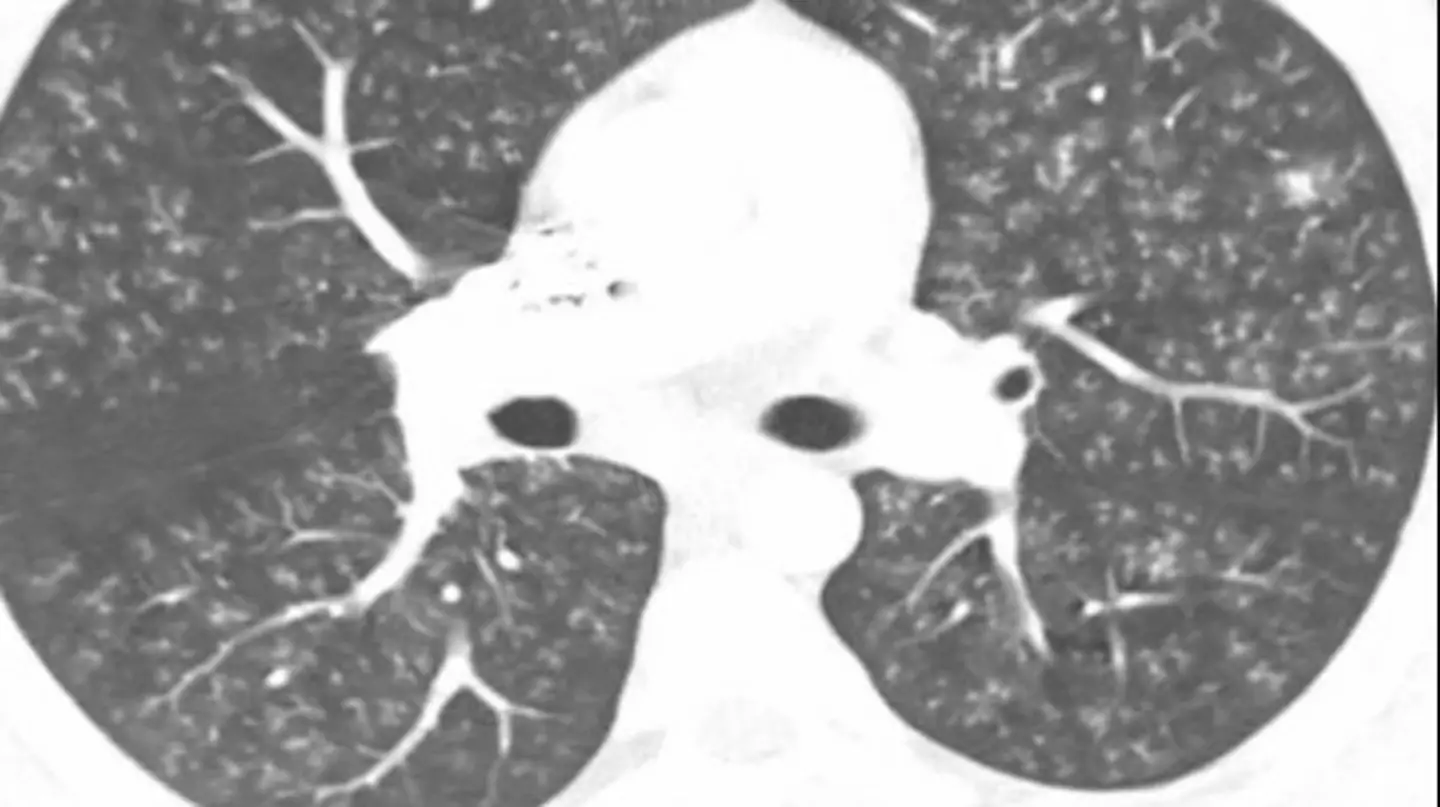
Radiology Masterclass

Health
Health news and advice, including the latest health stories and tips.

Entertainment
The latest entertainment news, TV, showbiz stories and gossip from the UK and worldwide.

Community
From feel good stories to unbelieveable real life events, we've got the latest community stories.